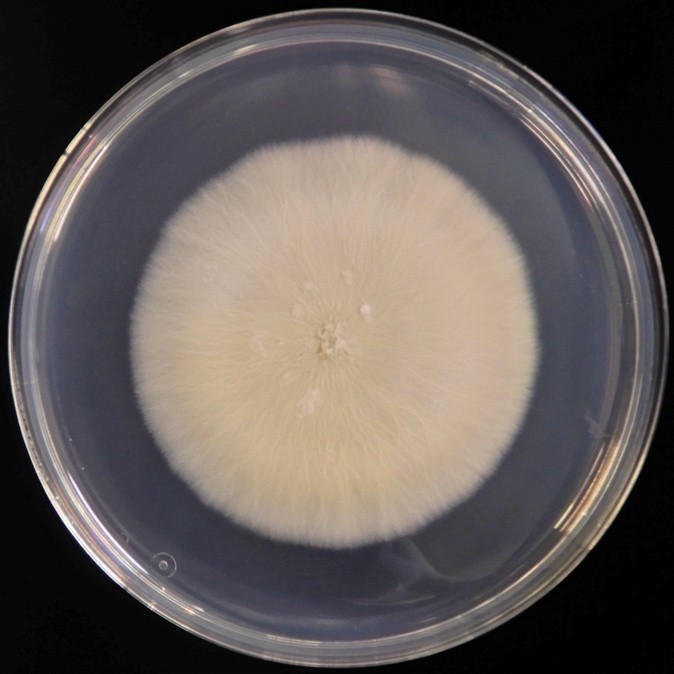
Fig. Sarocladium kilienseコロニー像 (ポテトデキストロース寒天培地、30℃、18日間培養)

Sarocladium kilienseによる真菌感染症
更新日 (last updated):2026年3月11日
概要
Sarocladium kilienseは土壌や水環境など自然環境中に広く存在する糸状真菌である。本真菌のヒトに対する病原性は低いが、免疫不全患者においては血流感染症・播種性感染症を呈した報告もある。また、外傷や白内障などに対する眼科手術後に眼感染症 (角膜炎・眼内炎) を生じることも報告されている。これらの真菌性眼感染症の臨床像は細菌性眼感染症と類似し診断が困難な場合も多く、また本真菌の抗真菌薬感受性は一般的に不良であるため治療に難航することも多い。適切な臨床検体採取・検査による早期診断と病態に応じた抗真菌薬治療・外科的手術などが重要である。
病原体
Sarocladium kilienseは子嚢菌門 (Ascomycota) フンタマカビ綱 (Sordariomycetes) ボタンタケ目 (Hypocreales) に属する糸状真菌である。以前は同目に属するAcremonium属に含まれていた (Acremonium kiliense) が、分子系統解析により現在はSarocladium属に再分類された [1]。Sarocladium kilienseは培地上では白色から淡橙色または淡褐色の、平坦からわずかに皺状のコロニー形成が特徴的とされる (Fig) [2]。これはAcremonium属および他のSarocladium属とは異なる特徴的な表現型であるが、形態学的な診断には高度な専門知識と経験が必要であるため、遺伝子検査により菌種を同定することが望ましい [3]。
疫学
Sarocladium kilienseは自然界に広く分布する腐生菌 (Saprophytic fungus) であり、土壌、水環境や植物、大気などから分離される環境真菌である [1, 4-6]。地理的には特定の地域に限定されず、世界各地から分離報告がある。
本真菌による感染症は散発例が大半であるが、化学療法中に使用する制吐剤のバイアル汚染による大規模なアウトブレイク例も報告されている [7]。また、医療器具や医療環境の水系汚染による院内感染の可能性を指摘した報告もあるが、これらの報告では分子疫学的手法による解析が不十分であり確定には至っていない [8, 9]。また、日本国内からの本真菌感染症に関する報告は症例報告にとどまる[10]。
感染経路および臨床像
Sarocladium kilienseは前述の通り環境中に広く存在する真菌である。本真菌に関する知見・症例報告は寡少であるため、以下では本真菌が含まれるSarocladium属・Acremonium属の感染経路および臨床像について概説する。
Sarocladium属・Acremonium属の病原性は低く、免疫正常者においては通常病原性を示さないか、限局性の感染症 (菌腫 <mycetoma>、爪真菌症、皮膚感染症、角膜炎など) にとどまる [3, 11, 12]。しかしながら、血液悪性疾患患者や固形臓器・造血幹細胞移植後などの免疫不全を有する患者や外傷・熱傷などにより皮膚・粘膜バリア機能が破綻した患者においては、環境中の真菌胞子の吸入や創部、血管留置カテーテルなど皮膚・粘膜バリア障害部位を主な侵入経路として全身性の侵襲性真菌症も呈することがある。環境中の胞子吸入に続発する肺感染症 (肺炎・膿胸など) を呈するほか、創部などからの侵入による皮膚軟部組織感染症、重症例では血流感染症や播種性感染を示すことも報告されている [11]。その他、骨髄炎、関節炎、中枢神経感染症や腸管感染症などが散発的に報告されている。
眼科領域におけるSarocladium属・Acremonium属感染症は角膜炎や眼内炎が報告されており、主として角膜外傷やコンタクトレンズ装用に伴う真菌性角膜炎や、白内障・硝子体手術や眼内注射などの手技後に発症する外因性眼内炎の様式で発症する [11-13]。角膜炎の症状としては、眼痛、視力障害、光過敏、前房蓄膿などが挙げられ、また眼内炎の症状としては、眼痛、飛蚊症、かすみ目・霧視、結膜充血、前房蓄膿などが挙げられる。いずれの病態でも進行例では網脈絡膜炎の合併により重篤な視力障害を呈する可能性があり注意を要する [13, 14]。
Sarocladium属・Acremonium属による角膜炎・眼内炎症例は複数報告されているが、真菌性眼感染症の原因菌としては非常に稀であり、報告により差はあるが、真菌性角膜炎全体に占める割合は総じて数%未満である [9, 14-18]。
病原体診断
Sarocladium kiliense感染症の診断においては、罹患部位から採取した臨床検体の培養や直接鏡検、病理組織学的検査などが必要である。角膜炎・眼内炎など眼科領域の感染症診断においては、角膜擦過物、前房水・硝子体液などの臨床検体を採取することが重要となる。前述の通り、Sarocladium kilienseはAcremonium属・他のSarocladium属とは異なる特徴的な表現型を呈し、培地上では白色から淡橙色または淡褐色の、平坦からわずかに皺状のコロニー形成が特徴的とされる [2]。また、培地に生育したコロニーや臨床検体の直接鏡検などでの分生子観察においては、楕円形から円筒形、透明で平滑な壁を有し粘液質の塊状を示すことが特徴的とされる。しかしながら、形態学的特徴のみでの同定は困難であることも多く、誤同定されることもあるため、確定診断には rRNA遺伝子領域 (Internal Transcribed Spacer領域およびD1/D2領域) 、translation elongation factor-1-alpha (tef-1a) 遺伝子、RNA polymerase II second largest subunit (rpb2) 遺伝子などを標的とした分子生物学的手法による同定が必要である [1, 19]。質量分析 (MALDI-TOF MS) による同定も報告されているが、結果の正確性はデータベースの整備状況に依存するため、用いる際は使用しているデータベースを確認することが重要である [20]。
治療
Sarocladium kiliense感染症に対する治療は、抗真菌薬の局所投与、経口投与または経静脈的投与などが病態に応じて選択される。本真菌による感染症は症例報告が大半であり、標準化された治療法は存在しない。血流感染症・播種性感染症においてはボリコナゾールやアムホテリシンBの経静脈的投与治療を行った症例報告が散見される [3, 10, 21]。
また、眼感染症の治療には、ケトコナゾール点眼やフルコナゾール点眼・経口投与、アムホテリシンB眼内 (硝子体内) 投与による抗真菌薬治療および角膜移植術や硝子体切除術などの外科的治療が病態に応じて実施される [9, 11, 13, 22]。
Sarocladium kilienseの抗真菌薬感受性データに関する報告は限られるが、いずれの報告でも全ての系統の抗真菌薬に対して高いMIC値を示す [2, 8, 23]。抗真菌薬治療に抵抗性を示す症例も少なくはなく、早期診断および外科的治療を含めた適切な治療方針の選定が予後改善のためには重要と考えられる。
予防法・ワクチン
現時点で使用可能なワクチンは存在しない。
法的取り扱い
感染症法、学校保健安全法では定められていない。
参考文献
- Summerbell RC, Gueidan C, Schroers HJ, de Hoog GS, Starink M, Rosete YA, Guarro J, Scott JA. Acremonium phylogenetic overview and revision of Gliomastix, Sarocladium, and Trichothecium. Stud Mycol. 2011; 68: 139-62. doi: 10.3114/sim.2011.68.06. PMID: 21523192.
- Perdomo H, Sutton DA, García D, Fothergill AW, Cano J, Gené J, Summerbell RC, Rinaldi MG, Guarro J. Spectrum of clinically relevant Acremonium species in the United States. J Clin Microbiol. 2011; 49(1): 243-56. doi: 10.1128/JCM.00793-10. PMID: 21068274.
- Pérez-Cantero A, Guarro J. Sarocladium and Acremonium infections: New faces of an old opportunistic fungus. Mycoses. 2020; 63(11) :1203-1214. doi: 10.1111/myc.13169. PMID: 33090564.
- Breyer E, Espada-Hinojosa S, Reitbauer M, Karunarathna SC, Baltar F. Physiological Properties of Three Pelagic Fungi Isolated from the Atlantic Ocean. J Fungi (Basel). 2023; 9(4): 439. doi: 10.3390/jof9040439. PMID: 37108894.
- Harish, Gopal Venkateshbabu, M.K. Prasannakumar, R. Karan, Pramesh Devanna, C. Manjunatha, Sarocladium kiliense: A first report of phytopathogenic fungus causing maize stalk rot in India, Physiol Mol Plant Pathol 2024; 134: 102449. doi: 10.1016/j.pmpp.2024.102449.
- Daussin A, Vannier P, Mater É, Šantl-Temkiv T, Cockell C, Marteinsson VÞ. Survival of Icelandic airborne microbes towards simulated atmospheric stress factors. Extremophiles. 2023; 27(2): 17. doi: 10.1007/s00792-023-01302-6. PMID: 37418077.
- Etienne KA, Roe CC, Smith RM, Vallabhaneni S, Duarte C, Escadon P, Castaneda E, Gomez BL, de Bedout C, López LF, Salas V, Hederra LM, Fernandez J, Pidal P, Hormazabel JC, Otaiza F, Vannberg FO, Gillece J, Lemmer D, Driebe EM, Englethaler DM, Litvintseva AP. Whole-Genome Sequencing to Determine Origin of Multinational Outbreak of Sarocladium kiliense Bloodstream Infections. Emerg Infect Dis. 2016; 22(3): 476-81. doi: 10.3201/eid2203.151193. PMID: 26891230.
- Ioakimidou A, Vyzantiadis TA, Sakellari I, Arabatzis M, Smias C, Douka V, Velegraki A, Anagnostopoulos A, Malissiovas N. An unusual cluster of Acremonium kiliense fungaemias in a haematopoietic cell transplantation unit. Diagn Microbiol Infect Dis. 2013; 75(3): 313-6. doi: 10.1016/j.diagmicrobio.2012.11.015. PMID: 23290506.
- Fridkin SK, Kremer FB, Bland LA, Padhye A, McNeil MM, Jarvis WR. Acremonium kiliense endophthalmitis that occurred after cataract extraction in an ambulatory surgical center and was traced to an environmental reservoir. Clin Infect Dis. 1996; 22(2): 222-7. doi: 10.1093/clinids/22.2.222. PMID: 8838176.
- Kitamura H, Kubota Y, Tomimasu R, Akashi M, Mori T, Mine Y, Ando J, Yamagata Murayama S, Kimura S, Miyahara M. Non-valvular Infective Endocarditis Caused by Sarocladium kiliense in an Immunocompromised Patient with Aplastic Anemia. Intern Med. 2022; 61(8): 1279-1283. doi: 10.2169/internalmedicine.7536-21. PMID: 34565770.
- Das S, Saha R, Dar SA, Ramachandran VG. Acremonium species: a review of the etiological agents of emerging hyalohyphomycosis. Mycopathologia. 2010; 170(6): 361-75. doi: 10.1007/s11046-010-9334-1. PMID: 20577905.
- Khan Z, Al-Obaid K, Ahmad S, Ghani AA, Joseph L, Chandy R. Acremonium kiliense: reappraisal of its clinical significance. J Clin Microbiol. 2011; 49(6): 2342-7. doi: 10.1128/JCM.02278-10. PMID: 21450966.
- Weissgold DJ, Orlin SE, Sulewski ME, Frayer WC, Eagle RC Jr. Delayed-onset fungal keratitis after endophthalmitis. Ophthalmology. 1998; 105(2): 258-62. doi: 10.1016/s0161-6420(98)92938-4. PMID: 9479284.
- Kim SW, Kim JH, Choi M, Lee SJ, Shin JP, Kim JG, Kang SW, Park KH; Korean Retina Society members. An Outbreak of Fungal Endophthalmitis After Cataract Surgery in South Korea. JAMA Ophthalmol. 2023; 141(3): 226-233. doi: 10.1001/jamaophthalmol.2022.5927. PMID: 36656597.
- Hohnen H, Davidoss N, Wiffen S, Radinger A, Tan SJ, Gardam D, Ang A. Retrospective Review of Fungal Keratitis at Two Tertiary Hospitals in Perth, Western Australia Between 2006 and 2022. Mycoses. 2025; 68(5): e70071. doi: 10.1111/myc.70071. PMID: 40407234.
- Lamas-Francis D, Navarro D, Mansilla R, de-Rojas V, Moreno C, Dios E, Rigueiro J, Álvarez D, Crego P, Rodríguez-Ares T, Touriño R. Fungal Keratitis in Northwestern Spain: Epidemiology, Risk Factors and Outcomes. J Fungi (Basel). 2024; 10(10): 689. doi: 10.3390/jof10100689. PMID: 39452641.
- Trinh T, Emami S, Gould J, Mimouni M, Cohen E, Rootman DS, Slomovic AR, Chan CC. Clinical and microbiological analysis of fungal keratitis in Toronto, Canada: A 20-year study. Med Mycol. 2022; 60(7): myac047. doi: 10.1093/mmy/myac047. PMID: 35749577.
- Ahmadikia K, Aghaei Gharehbolagh S, Fallah B, Naeimi Eshkaleti M, Malekifar P, Rahsepar S, Getso MI, Sharma S, Mahmoudi S. Distribution, Prevalence, and Causative Agents of Fungal Keratitis: A Systematic Review and Meta-Analysis (1990 to 2020). Front Cell Infect Microbiol. 2021; 11: 698780. doi: 10.3389/fcimb.2021.698780. PMID: 34513726.
- Hou LW, Giraldo A, Groenewald JZ, Rämä T, Summerbell RC, Huang GZ, Cai L, Crous PW. Redisposition of acremonium-like fungi in Hypocreales. Stud Mycol. 2023; 105: 23-203. doi: 10.3114/sim.2023.105.02. PMID: 38895703.
- Wei L, Shao J, Song Y, Wan Z, Yao L, Wang H, Yu J. Performance of Matrix-Assisted Laser Desorption Ionization-Time of Flight Mass Spectrometry for Identification of Scedosporium, Acremonium-Like, Scopulariopsis, and Microascus Front Microbiol. 2022; 13: 841286. doi: 10.3389/fmicb.2022.841286. PMID: 35308359.
- Díaz-Couselo FA, Zylberman M. Catheter-Related Acremonium kiliense Fungemia in a Patient with Ulcerative Colitis under Treatment with Infliximab. Case Rep Infect Dis. 2011; 2011: 710740. doi: 10.1155/2011/710740. PMID: 22567476.
- Weissgold DJ, Maguire AM, Brucker AJ. Management of postoperative Acremonium endophthalmitis. Ophthalmology. 1996; 103(5): 749-56. doi: 10.1016/s0161-6420(96)30620-9. PMID: 8637683.
- Trovato L, Rapisarda MF, Greco AM, Galata F, Oliveri S. In vitro susceptibility of nondermatophyte molds isolated from onycomycosis to antifungal drugs. J Chemother. 2009; 21(4): 403-7. doi: 10.1179/joc.2009.21.4.403. PMID: 19622458.
